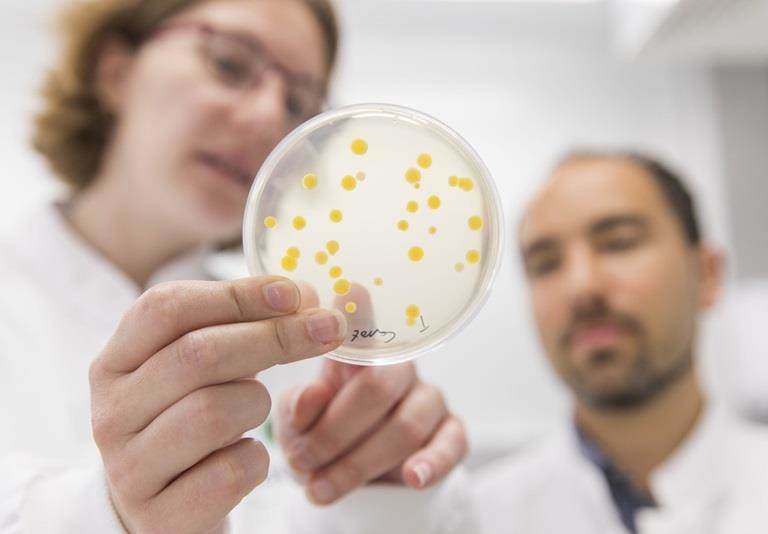

About us
It is our mission to provide innovative crop protection and seed enhancement technologies, enabling the agricultural community to improve agricultural yields and contribute to global food security.
Our biobased and low-carbon delivery systems help to improve agricultural yields whilst minimising environmental impact. We help optimise land and crop input utilisation via our adjuvants, delivery systems, and seed technologies, and support the transition to regenerative agriculture practices through our range of sustainable, innovative solutions.
Adjuvants and coformulants
We provide sustainable delivery systems for agrochemical active ingredients, both chemical and biological-based. Our high-performance formulation aids and novel range of adjuvants mean that you can accomplish even the most challenging formulations.
Products | Formulations | Technologies
Seed enhancement
Our solutions improve the resilience and performance of seeds and decrease the need to use plant protection products. Focusing on vegetable and field crops, our seed technologies improve germination, stimulate the healthy development of seeds and seedlings, and increase crop yield.
Biostimulants
Our novel, chemical biostimulant products improve crop quality, yield, and shelf life, helping growers to grow more food without using more land and reducing waste.

How Croda Agriculture supports crop and seed enhancement
Spray quality control
Precision targeting, reduced product waste and off target drift
Resilience
Mitigate effects of abiotic stress
Input performance
Improved penetration and delivery of active ingredients
Nutrient uptake and mobility
Enhanced uptake and delivery of essential nutrients
Optimise seed performance
Efficient protection of seed, quicker and more uniform germination
Soil health
Efficient penetration of water and agrochemical treatments
What are our services?
Capabilities

Market areas

Product validation centre

Laboratory support

Industry relevant formulations

Hands on training

Seed enhancement
Enhancing the quality of the seed gives crops the best chance of reaching their full genetic yield potential. This can be done by stimulating their growth and development and protecting them from biotic and abiotic stresses, such as pests, disease, and adverse growing conditions.
As part of Croda Agriculture, seed enhancer Incotec, specializes in developing and using seed technologies to improve the performance and resilience of seeds. These technologies include seed pelleting, encrusting, film coating, priming, upgrading, and seed hygiene.

Biostimulants
At the forefront of plant science, we develop advanced chemical biostimulants that work in harmony with natural plant processes. Designed to support existing crop protection programs, our solutions help improve crop quality, boost yields, and extend shelf life.
By supporting or regulating plant responses, our biostimulants promote healthier growth—even under stress—ensuring crops perform well in both ideal and tough conditions.

The next 25 years: Smart science and sustainable innovation in Agriculture

Join the CrodaON experience
CrodaON is your trusted partner for managing your orders with Croda, offering the security, transparency, and efficiency you need.
Currently, CrodaON is available to our existing customers. If you are placing your first order and are interested in using CrodaON, we’d love to discuss how we can support you. Our sales representatives are ready to assist and guide you through the process.
Start your journey with CrodaON today by connecting with our team and experiencing the benefits of seamless order management.